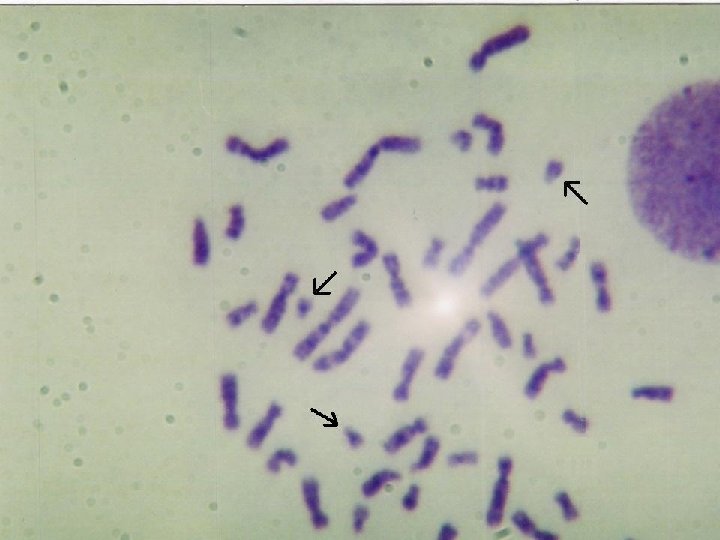

CARITIPO Genoma Humano Conjunto de haploides da espcie






















- Slides: 22

CARIÓTIPO

Genoma Humano – Conjunto de haploides da espécie humana



Cariótipo/Idiograma Conceito Conjunto de cromossomos contidos nas células de um organismo, organizados em ordem decrescente de tamanho. Sp. Humana = 46 cromossomos Células somáticas - diploides(2 n).

Característica Morfologicamente, os cromossomos são identificados, diferenciados e classificados quanto ao tamanho e localização do centrômero (região do cromossomo intermediária aos braços simétricos ou assimétricos, curtos ou longos).

Classificação dos cromossomos Metacêntrico → Centrômero posicionado no centro do cromossomo; Submetacêntrico → Centrômero deslocado para uma das extremidades do cromossomo; Acrocêntrico → Cromossomo portador de uma esfera terminal (satélite), localizada na extremidade do braço curto; Telocêntrico → Cromossomo formado por apenas um braço, com centrômero estritamente terminal.


Característica Para determinação e visualização do cariótipo, sendo possível quantificar o número típico de cromossomos de uma espécie, é necessária a interrupção do processo de divisão celular no momento da metáfase, fase na qual os cromossomos atingem o máximo de condensação – uso de substâncias mitogênicas - fitohemaglutinina e colchicina.



Como é realizado o exame: Amostras de sangue, medula óssea, líquido amniótico ou tecido placentário. Os cromossomos contêm milhares de genes armazenados no DNA. A amostra é colocada para crescer em uma cultura de tecido, em laboratório; a seguir, as células são colhidas e recebem um corante para poderem ser analisadas no microscópio. As células são fotografadas para se obter o cariótipo. As anormalidades podem ser identificadas conforme a organização dos cromossomos.

Classificação Universal de Denver Grupos Morfologia Pares A Grandes - Metacêntricos ou Submetacêntricos 1 a 3 B Grandes – Submetacêntricos 4 e 5 C Médios – Submetacêntricos 6 a 12 – X D Médios -Acrocêntricos 13 a 15 E Pequenos – Metacêntricos ou Submetacêntricos 16 a 18 F Pequenos – Submetacêntricos 19 e 20 G Muito Pequenos – Acrocêntricos 21 e 22 -Y



Cariótipos - Notação Cariótipo de um homem → 22 AA + XY ou 46, XY Cariótipo de uma mulher → 22 AA + XX ou 46, XX Número de cromossomos encontrados vírgula cromossomos sexuais.



A

B

C